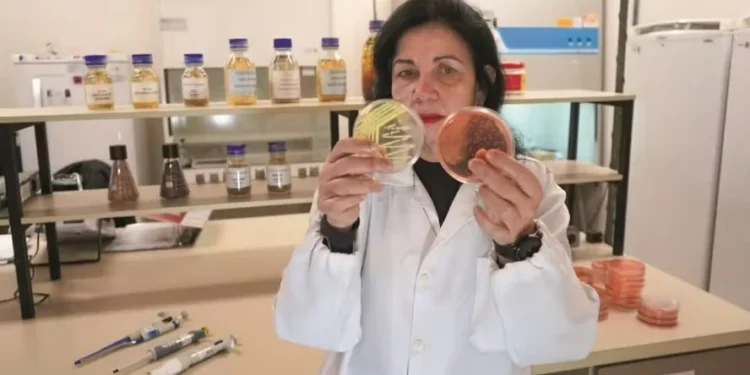
Pesquisa com microrganismo rendeu a Mariangela Hungria vários reconhecimentos internacionais — Foto: Luciano Pascoal

A pesquisadora brasileira Mariangela Hungria, da Embrapa Soja, está na lista das 100 pessoas mais influentes do mundo em 2026, editada pela revista americana Time. Ela aparece entre os classificados como “pioneiros” pelo seu trabalho com microbiologia e fixação biológica do nitrogênio.
“Hoje, graças ao seu trabalho, 85% da soja brasileira é cultivada com esses microrganismos em vez de fertilizantes sintéticos. Suas inovações ajudaram agricultores brasileiros a economizarem US$ 25 bilhões por ano”, destaca Kyla Mandel, editora sênior da Time, no texto sobre a pesquisadora.
Formada em engenharia agronômica na Escola Superior de Agricultura Luiz de Queiroz (Esalq-USP) em 1979, Mariangela Hungria trabalha desde julho de 1981 na Embrapa Soja, em Londrina (PR). Na cidade, ela também deu início à carreira de professora, na Universidade Estadual de Londrina (UEL).
A cientista é doutora em Ciência do Solo pela Universidade Federal Rural do Rio de Janeiro (UFRRJ), pós-doutora em microbiologia na Universidade de Cornell (EUA) e em fitoquímica e sinalização molecular plantas-microrganismos na Universidade da Califórnia, também nos EUA. Ela recebeu um terceiro PhD na Universidade de Sevilha (Espanha).
O trabalho da cientista já lhe rendeu outros reconhecimentos internacionais. No ano passado, ela conquistou o Prêmio Mundial da Alimentação, pela sua contribuição para o desenvolvimento de insumos biológicos para a agricultura. Foi a primeira mulher brasileira a ser premiada.

Mariângela Hungria: ‘Há muitas soluções. Precisamos de parceiros’
Antes, apenas três representantes do Brasil receberam a nomeação. Em 2006, o ex-ministro da Agricultura, Alysson Paolinelli e o agrônomo Edson Lobato dividiram o prêmio com o colega estadunidense A. Colin McClung, pelo trabalho de desenvolvimento da agricultura na região do Cerrado.
Em 2011, dois ex-presidentes – Luiz Inácio Lula da Silva, do Brasil, e John Kufuor, de Gana, foram os escolhidos pelo trabalho com a erradicação da fome em seus países.